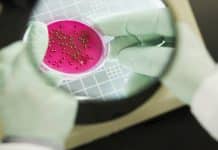
Scientists develop Novel rapid test for Bacterial Infections

British Botanists Warn That The Plant World Is Under Threat
British Botanists Warn That The Plant World Is Under Threat
Britain's Royal Botanic Gardens warned Tuesday about the threats facing the world's plant kingdom in...
World on the Brink of Yellow Fever Outbreak Emergency
World on the Brink of Yellow Fever Outbreak Emergency
Urgent action is needed to combat a yellow fever epidemic in Africa amid signs it is...
Improve Your Skin’s Elasticity By Wearing a Film
Improve Your Skin's Elasticity By Wearing a Film
For those concerned about wrinkly old skin, it might be an ingenious solution: a stretchy “second skin”...
Bacteria Came to the Rescue After the Devastating Oil Spill in 2010
Bacteria Came to the Rescue After the Devastating Oil Spill in 2010
Microscopic bacteria played a crucial role in the cleanup of the devastating 2010...
Zika Virus Hijacks the Human Immune molecule | Causes Microcephaly
Zika Virus Hijacks the Human Immune molecule | Causes Microcephaly
After lot of examination, the U.S. Centers for Disease Control and Prevention have recently concluded...
The Sniffer Car : A Car that can smell Chemicals a Quarter Mile Away
The Sniffer Car : A Car that can smell Chemicals a Quarter Mile Away
You might have heard of sniffer dogs that can smell chemicals...
There is Future in Biotech / Life Sciences Industry , Here is the Proof...
Scene 1:
New Delhi | 11th May 2050
Today 2 Terrorist Organizations attacked the Out Skirts of the National Capital with Mutagenic Influenza Virus and as...
Scientists develop Novel rapid test for Bacterial Infections
Scientists develop Novel rapid test for Bacterial Infections
Researchers from Massachusetts General Hospital (MGH) in Boston, US have recently developed a device with the potential of...
Notification For CSIR – Raman Research Fellowships for the year 2016-2017
CSIR - Raman Research Fellowships for the year 2016-2017
Applications are invited from CSIR institutes for the award of Raman Research Fellowships for the year 2016-2017....
FDI in food : Govt may permit foreign companies to import ingredients
FDI in food : Govt may permit foreign companies to import ingredients
In the coming days, the government is expected to permit foreign companies to import...
A New Treatment for HIV May be Possible Through Antiretroviral Therapy
A New Treatment for HIV May be Possible Through Antiretroviral Therapy
The development of antiretroviral therapy, a combination of drugs that slows the replication of...
Scientists Say Bacteria Can Reveal How Birds Got Their Wings
Scientists Say Bacteria Can Reveal How Birds Got Their Wings
The evolution of major novel traits - characteristics such as wings, flowers, horns or limbs -...
Scientific Breakthrough – Scientists Visualize Disease Proteins Being Born
Scientific Breakthrough - Scientists Visualize Disease Proteins Being Born
For the first time, scientists at Albert Einstein College of Medicine have developed a technology allowing...
ICAR Looks Into Drought-Resistant GM Sugarcane
ICAR Looks Into Drought-Resistant GM Sugarcane
The central government's premier research institution - Indian Council of Agricultural Research (ICAR) - is joining hands with the...
The Cellular Orchestra : Researchers find Cells check DNA segregation at the end of...
The Cellular Orchestra : Researchers find Cells check DNA segregation at the end of their division
The cells in our bodies are constantly dividing. From...